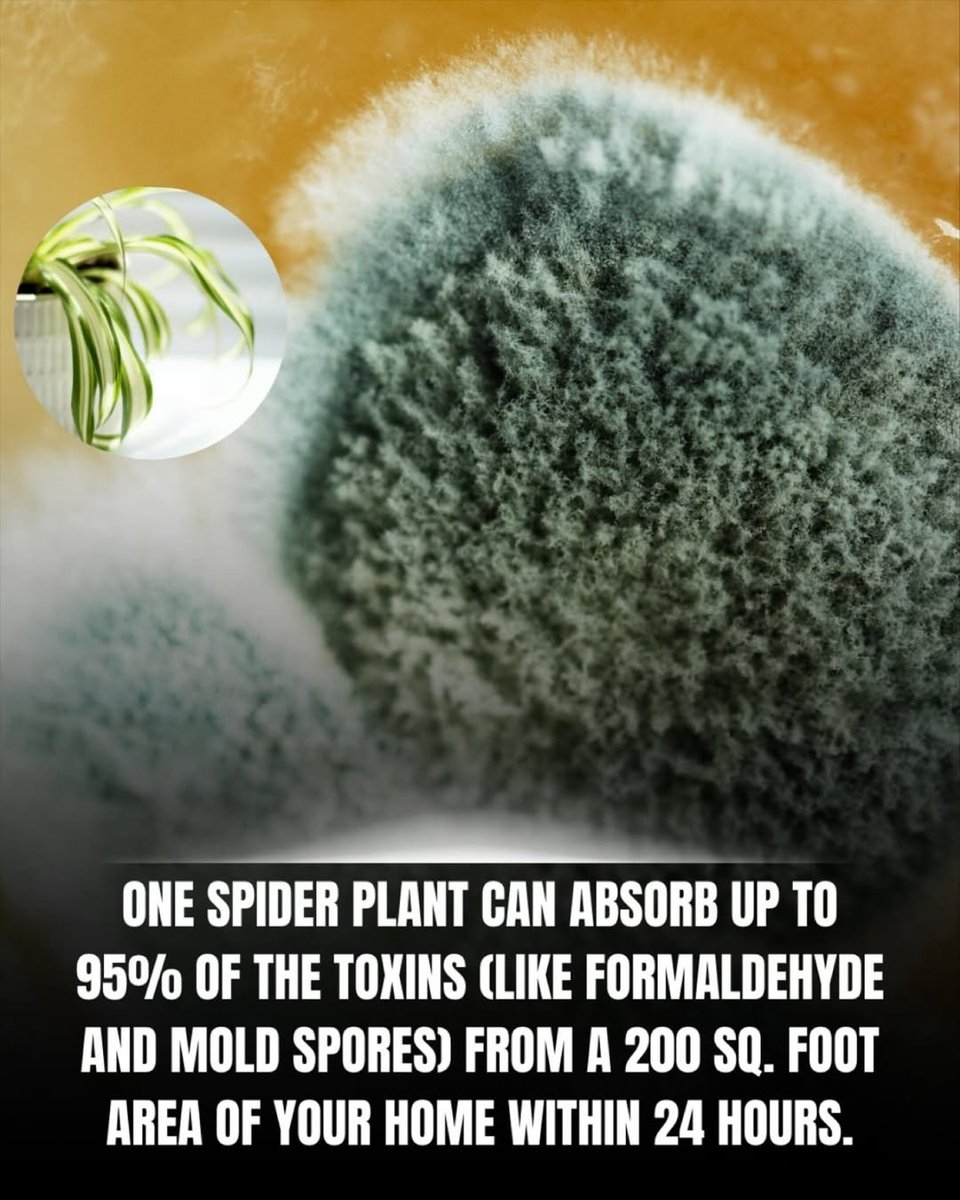

Daniel
@daniel78921455
ID: 1470860044203876355
14-12-2021 20:57:51
1,1K Tweet
30 Takipçi
18 Takip Edilen










The American Heart Assn. Has Changed 'Normal' Blood Pressure To 110/70...Every Time They Lower The Numbers, Millions Of People Need Drugs. In 1970, Normal BP Was 160/95. In 1985 It Was 140/90. And Now 120/80 Is Considered 'Elevated.' That's Not Medicine. That's $40B Marketing.